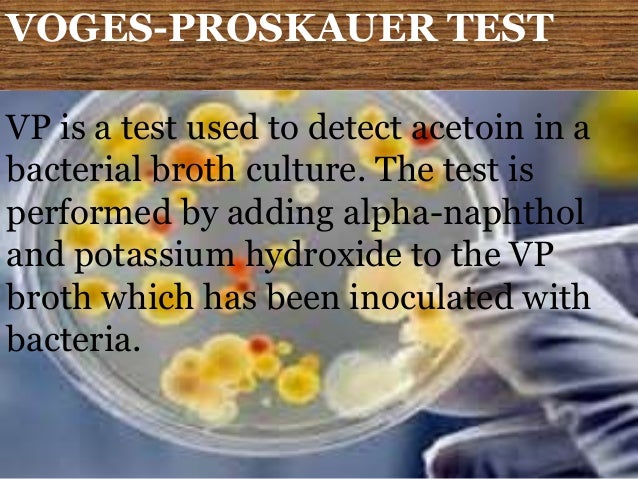
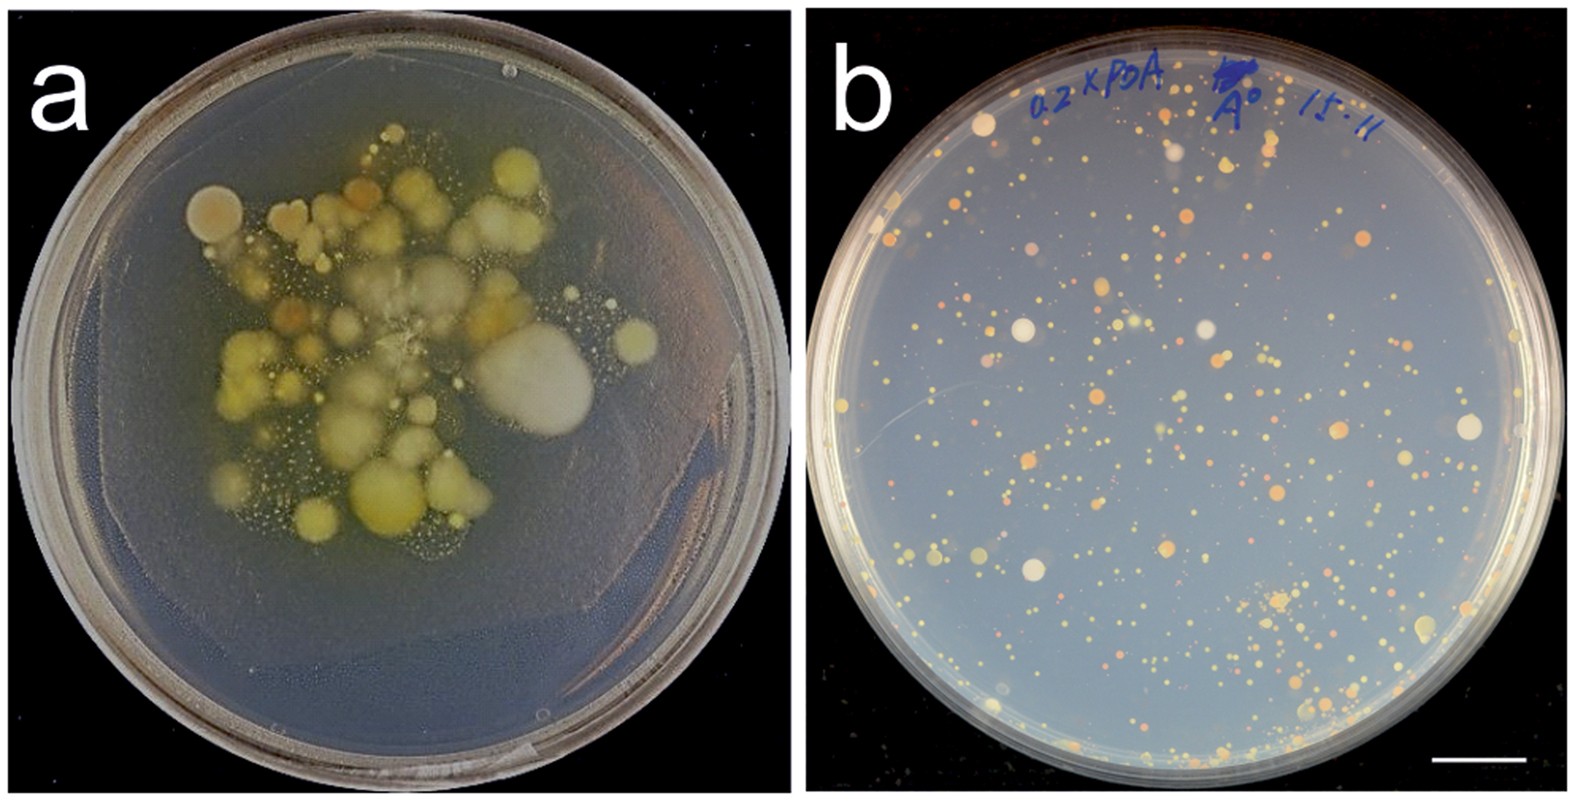

Cook Your Own Microbial Growth Plates 8 Steps With Pictures
2

Methyl Red Mr Test Principle Procedure And Result Interpretation

Thermal Inactivation Of Listeria Monocytogenes In Whole Oysters

Buffered Dilution Water At Thomas Scientific

Prepared Media Tubes Thermo Fisher Scientific Australia

Liquefaction Resistance Of Fraser River Sand Improved By A
Http Www Wardsci Com Assetsvc Asset En Us Id 14649274 Contents
Https Beta Static Fishersci Com Content Dam Fishersci En Us Documents Programs Education Brochures And Catalogs Brochures Carolina Biological Techniques Studying Bacteria Fungi Brochure Pdf

Peptone Yeast Extract Glucose Broth Culture Media Online

De202004016646u1 Lozenge Used For Topical Treatment Of

Tm Media Products Catalog 2018 Products List

Buffered Dilution Water At Thomas Scientific

Food Industrial Microbiology 1 Rapid Method Direct Epifluorescent

Cultural Physiological And Biochemical Identification Of
Https Www Flinnsci Com Api Library Download 18ce587821c24fb3b0ad7d878bd6a3d9
Growth Media Recipes Growth Medium Agar

The Role Of Caulobacter Cell Surface Structures In Colonization Of
Https Www Epa Gov Sites Production Files 2015 08 Documents Method 1103 1 2010 Pdf
Icomst 2019 Online Program
Demonstration Of Methyl Red And Voges Proskauer Test
Https Www Flinnsci Com Api Library Download 18ce587821c24fb3b0ad7d878bd6a3d9

Preparation Of Actinoplanes Missouriensis Zoospores And
Icomst 2019 Online Program
Physicochemical And Microbiological Characteristics Of Diverse
The Isolation And Characterization Of Resident Yeasts From The

Molecules June 2017 Browse Articles
Https Www Romerlabs Com Shop Inter En Romerlabs Msds Filedownload File Id 7bbedd44342541009cceb41784accc7f

771 Questions With Answers In Agar Science Topic

3 Slime Production By An Obligate Thermophile Aeribacillus

Plant Growth Promoting Bacteria Pgpb Isolation And Screening Of

Preparation And Sterilization Freshney Major Reference Works

Saccharomyces Cerevisiae Populations And Other Yeasts Associated
Frontiers Rugose Morphotype In Salmonella Typhimurium And
Https Www Ponteproject Eu Wp Content Uploads 2018 02 Booklet Protocols Workshop Anses 2018 Pdf
Http Www Wardsci Com Assetsvc Asset En Us Id 14649274 Contents
Http 2018 Igem Org Wiki Images B B9 T Usafa Bench Pdf

De102004052308a1 Octenidine Containing Lozenges Against

Tos Propionate Agar Medium Yakult Pharmaceutical Industry Co Ltd
No comments:
Post a Comment